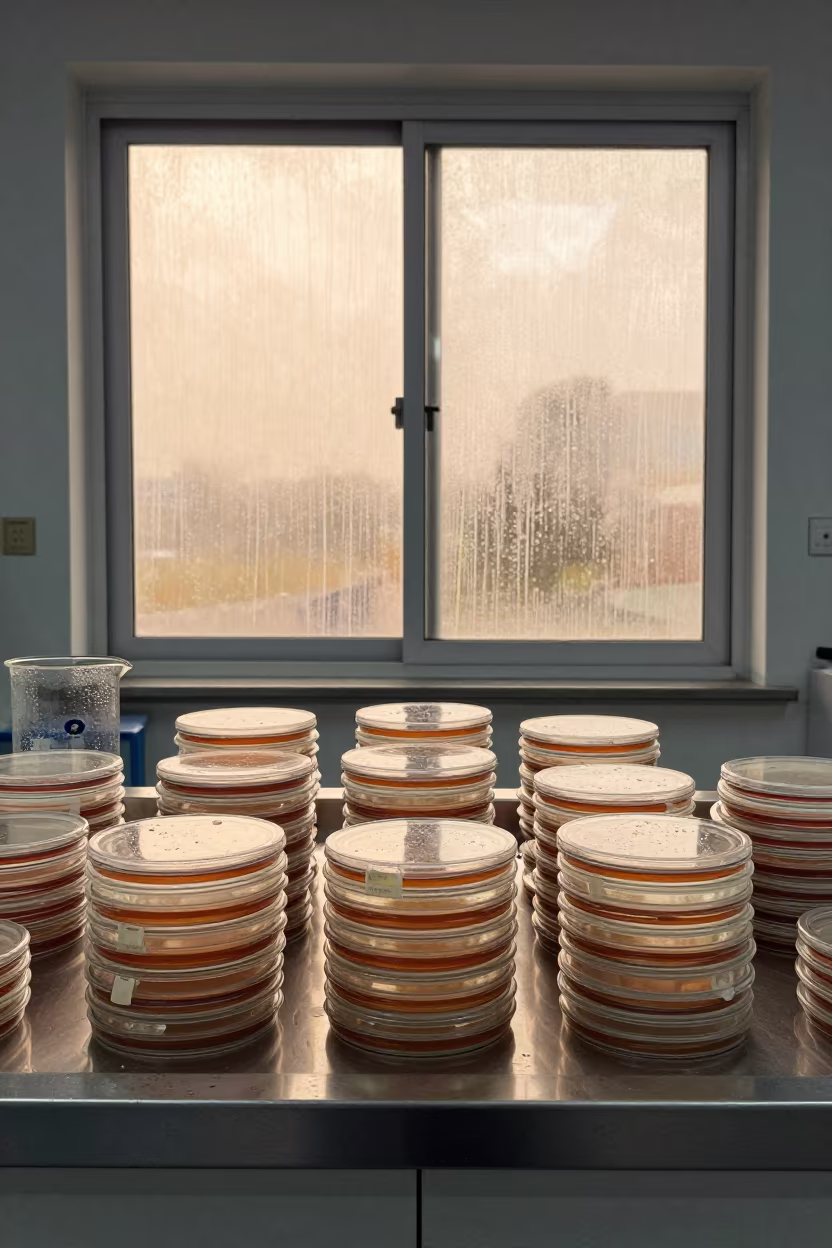
Petri Dish Stack Shadows in Rome Lab in inside a clean room in Rome

Petri Dish Stack Shadows on Lab Bench
by Ethan Garza
Clean laboratory light floods the stainless steel surface of a workbench, illuminating a vertical stack of petri dishes. Circular glass containers rest atop one another, their clear edges catching the bright midmorning sun. Sharp, round shadows stretch across the metallic table, defining the scale of the glassware against the vast negative space. Muted reflections ripple along the polished floor beneath the bench, hinting at the observatory control room setting in Gwalior. The late spring atmosphere settles on the precise, analytical calm of the scene. A faint green tint on the agar inside the bottom dish marks the edge of the nearest container.
<a href="https://img.veeter.com/petri-dish-stack-shadows-lab-bench"><img src="https://cdn.veeter.com/img/petri-dish-stack-shadows-lab-bench" alt="Petri Dish Stack Shadows on Lab Bench in inside an observatory control room in Gwalior"></a>
Free to download. CDN hosting requires a link back to this page. Terms
Similar Images

Petri Dish Stack Shadows Lab Bench Brasilia
Sony a6700 · at a microscopy bench in Brasilia
Petri Dish Stack Shadows in Rome Lab
Google Pixel 5 · inside a clean room in Rome

Petri Dish Stack Shadows on Lab Bench
Sony ZV-1 · at a microscopy bench in Dhaka

Petri Dish Shadows on Lab Bench
iPhone 13 Pro · inside a university research lab near Chittagong

Stacked Petri Dishes Cast Round Shadows on Lab Bench
iPhone XS · at an engineering workbench in Hillah

Petri dishes drying on pads near lab timer
Minolta X-700 · at an engineering workbench near Belo Horizonte

Petri Dish Rack With Tagged Tubes in Lab
Minolta X-700 · inside a university research lab near Gyeongju

Petri Dish Shadows and Uphill Water Flow
iPhone 13 mini · inside a university research lab in Vienna

Petri Dishes Stack Beside Incubator in Dessie Lab
Sony NEX-7 · at a microscopy bench in Dessie

Petri Dishes Stack Beside Incubator in Beni Suef Lab
Canon T90 · in a specimen archive room in Beni Suef

Petri Dishes Drying on Lab Bench Timer
Olympus OM-10 · inside a clean room in Weimar

Sleepy Scientist Carries Petri Dish Stack in Divo Dawn
OM System OM-5 · in Divo

Microscope Slides and Staining Solution in Bhilai Lab
Sony NEX-7 · inside a clean room near Bhilai

Tripod Head Brass Fittings Aligarh Lab
Lubitel 166 universal · at a microscopy bench near Aligarh

Petri Dish Smear Plate Lab Glove Box
Mamiya RB67 · inside a university research lab in Nizhny Novgorod

Petri Dishes Drying on Lab Bench in Manila Twilight
Nikon D810A · at a microscopy bench in Quiapo, Manila

Lab Colony Ringed by Condensation Under Fluorescent Light
Nikon FM3A · at an engineering workbench in Hillah

Petri Dish Colony Under Lab Light
Leica M9 · at a microscopy bench in El Jadida

Sunset Lab Bench with Glassware and Notes
Olympus Trip 35 · in a bright laboratory in Nagpur

Petri Dish Culture on Stainless Tray Near Solapur
Canon EOS 80D · near Solapur

Teacher Sets Goggles and Petri Dishes on Seminar Table
Fujifilm X-H2 · at a seminar table covered in notes in Nadiad

Magnifying Glass on Oak Lab Bench
Zorki 4 · at an engineering workbench near 6th of October

Decaying Lab Bench in Faisalabad Courtyard Dawn
Canon EOS 650D · through a courtyard reclaimed by grasses near Faisalabad

Petri dishes drying on pads in Al Hudaydah lab
Sony a6100 · inside an observatory control room in Al Hudaydah

Amber Vials and Pipettes on Science Bench
iPhone 14 · at a microscopy bench in Körfez

Microscope Turret and Plankton Jars in Dawn Light
Pentax K10D · in a bright laboratory near Bangalore

Teacher Sets Lab Gear at Mandalay Seminar Table
iPhone 12 Pro Max · at a seminar table covered in notes near Mandalay

Petri Dish Colony with Condensation on Workbench
Hasselblad 907X · at an engineering workbench in Bucharest

Petri Dish Smear Plate in Iloilo Lab
Polaroid 636 · in a bright laboratory in Iloilo

Slide Viewer on Oak Lab Bench in Observatory
Sony a7 · inside an observatory control room near Anaco

Lip Gloss Tester Tray in Kunming Skincare Room
Sony NEX-7 · inside a skincare treatment room in Kunming

Pink Stained Lab Sink Under Candlelight
iPhone X · at a microscopy bench near Araure

Laboratory Bench Flasks Bonn Observatory
Nikon F5 · inside an observatory control room in Bonn

Dawn Light on Beijing Lab Bench
Nikon F6 · inside a clean room in Beijing

Lab Bench Flasks Notes Pipettes Bamako Noon
Sony a7 III · in a bright laboratory in Bamako

Scientist Carries Petri Dish Stack Through Kasama Dawn Mist
iPhone 11 · in Kasama

Orange Glow Chemistry Lab Monsoon Morning Osaka
Fujifilm GFX100S II · in a bright laboratory near Osaka

Sterile Surgical Tray Setup at Nurse Station Lahore
Nikon D90 · at a nurse station under monitor glow near Lahore

Oak Lab Bench Slide Viewer With Brass Details
Canon EOS 7D Mark II · at a microscopy bench near Ulsan
Comments